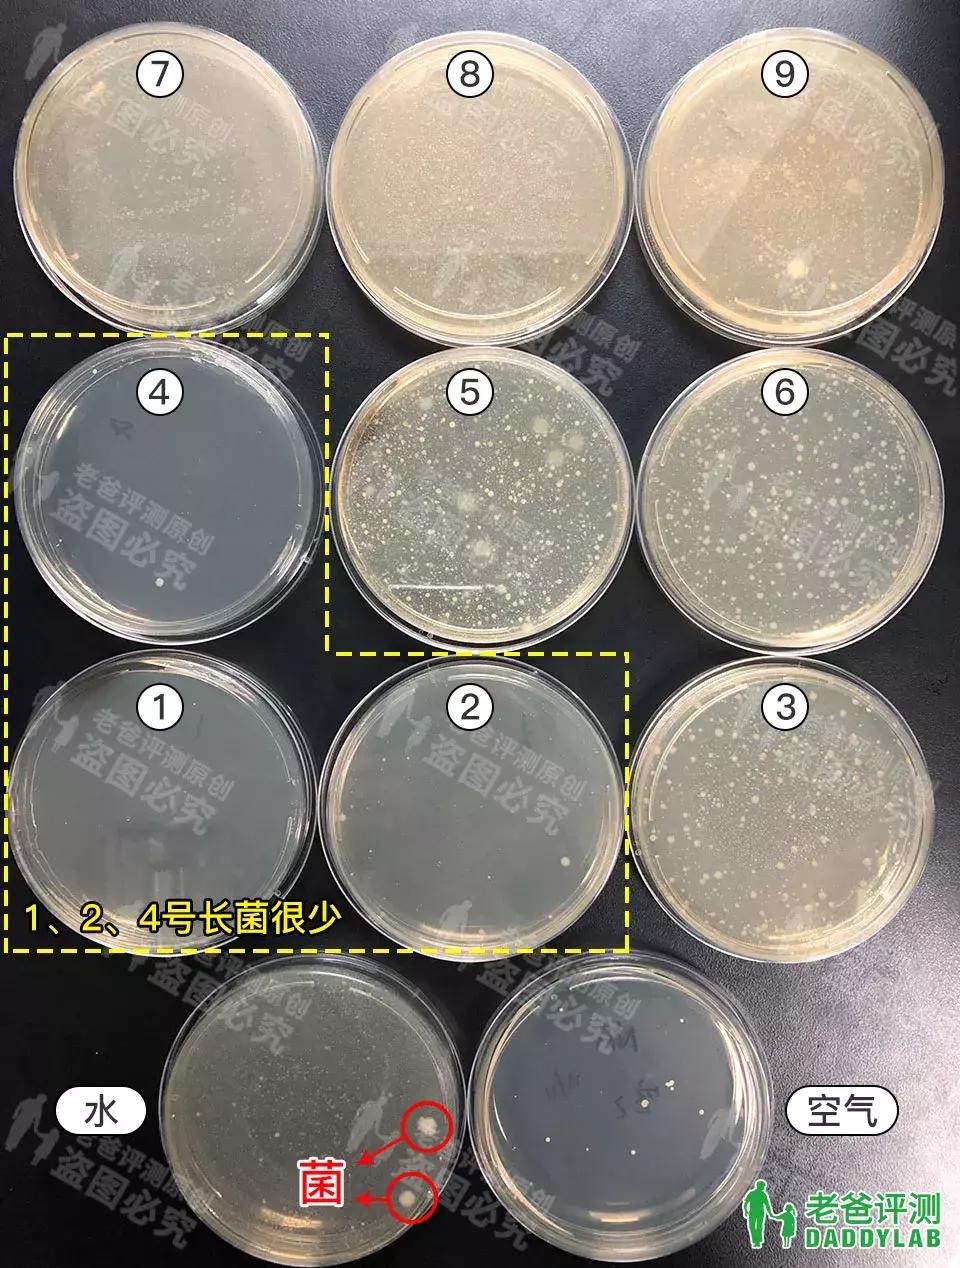
魏老爸测评戴森空气净化加湿器,加湿器推荐评测戴森

我是魏老爸,一个用检测手段发现身边看不见的危害的杭州普通家长,欢迎关注我的头条号。

这次给家评测加湿器!百来块的、大几千的、超声波的、除菌的......到底选哪个?差别在哪里?会产生雾霾吗?这次我购买了 12 款国内外品牌的加湿器进行评测。


检测时间:2018.11.11 - 2018.12.17
检测地点:杭美实验室、老爸评测实验舱
样品费 + 检测费:8738 + 3600 = 12338 元
样品来源:京 D 旗舰店、T 猫旗舰店
如果觉得对你有帮助,欢迎在文章底部进行打赏
现在的加湿器主要有两类:
一种是超声波加湿器,也是加湿器中最常见的一种,以戴 S、Z 米、德 E 玛、X 熊等为代表,通过高频震荡将水打散为细小的颗粒。我们平时能看见水雾的加湿器就是这种。

还有一种是冷蒸发加湿器,最大的特征是看不到水雾。以斯 T 得 L、美 D、飞 L 浦为代表,通过循环风将液态水变成气态水,实现加湿效果。这次购买的加湿器中,9 款是超声波的,3 款是冷蒸发的。
--接下来开始测试!--
一、加湿能力测试
加湿器的加湿能力,即“加湿量”。我们检测了每个加湿器在 1 小时内的加湿量(加湿器加湿前后重量变化、开最大档),并与产品标注的额定加湿量相比较。


▲ 实验实拍
结果如下:

私信发送:加湿器 查看具体品牌
① X 熊加湿器除菌模式下加湿量最高,有 400g/h,由于是加热除菌模式,出来的是暖雾。
② 亚 D 这款加湿器加湿量最低,仅有 49g/h,与产品标注的额定加湿量 240ml/h 差太多了。
③ Z 米和海 E 两款加湿器的加湿量与额定加湿量也有一定差距。
④ 戴 S、格 L 等其它几款加湿量在 200 - 300 之间,与额定加湿量相差不是很多。
注: 加湿量大小只代表加湿器排出了多少水,还是要看实际加湿效果。
二、实际加湿效果测试
为了模拟家庭环境,我们在老爸评测 12m² 的实验舱检测加湿器的加湿效果,即单位时间的湿度变化。

温度对湿度影响比较大,所以我们将实验舱内温度严格控制在 27±1℃。调节实验舱内初始湿度在 35% 左右,待湿度稳定,记录初始湿度、温度。

开启加湿器最大档,1 小时后取实验舱内 3 个点的湿度值计算,并记录下来。
结果如下:

私信发送:加湿器 查看具体品牌
整体看,超声波加湿器比蒸发加湿器加湿效果稍好一点,但差距也不大。亚 D 这款加湿器的加湿效果相对差一些,一小时湿度变化仅有 7.9%,其它几款加湿器湿度变化在 20% 左右。
样品中最便宜的 136 元,最贵的 3760 元,价格差距如此大,加湿效果却差不多......唉,看来品牌溢价真是贵啊...
三、除菌加湿器真能除菌吗?
加湿器的水放久之后,容易长菌,不及时清理的话,这些细菌会随加湿器喷出的水雾飘散在空气中。所以现在很多厂家推出了“升级版”加湿器,宣称通过紫外、抑菌盒子、银离子过滤网等起到除菌抑菌的作用。比如这几种:

▲ 产品官方店宣传图

▲ 产品官方店宣传图

▲ 产品官方店宣传图
在评测的 12 款加湿器中,就有 9 款是厂家宣称有除菌抑菌作用的。这些加湿器效果怎么样呢?它们真的能除菌么?加湿器喷出来的水雾会不会有菌呢?
除菌测试过程
我们给每个加湿器加入相同的自来水(自来水提前放置室内三天,已测试有菌),开启加湿。

对于超声波加湿器,采用无菌袋在加湿器出气口处取样;对于冷蒸发加湿器,运行 2 小时后,在水箱中取样。



同时,我们也对实验用的自来水和室内空气进行了取样,做对比参照。取样后,进行细菌培养,两天后观察结果。

经过两天的培养后,可以看到平面皿里出现了大大小小的白点,这些就是菌。
除菌样品编号:1#戴s;2#z米;3#德E玛;4#X熊;5#美L;6#海E;7#飞L浦;8#美D;9#斯T得L
作为对比参照的自来水中明显有菌,实验环境的空气中细菌不多。
1 号、2 号、4 号长菌很少,或几乎没有菌,这说明1、2、4 号加湿器除菌效果好,可保证加湿器喷出的水雾是无菌的。
其它几款都长满了大大小小的菌落,对水中的菌作用不明显,除菌效果差。使用这几款加湿器的朋友要记得及时清理、换水。
值得一提的是,戴 S、Z 米是通过紫外杀菌的,而 X 熊是通过高温除菌,出来的是暖雾,所以它的功率最大,加湿量也是最高的。

▲ X 熊除菌机理图源于网络
另外有两款加湿器,宣称靠银离子盒子杀菌,我们对这俩盒子进行了 XRF(X 射线荧光光谱)扫描。

扫描显示白色盒子里银有 957143ppm,黄色盒子里银有 8608ppm(其实主要是铁、镍、铬)。


▲ 左为黄色盒子数据,右为白色盒子数据
我们都知道,银离子有杀菌、抑菌的作用。但还真不知道,测出的这两个含量,会不会起到如此效果。还请各位大咖评论区指教。
四、加湿器会产生雾霾?
听说自来水里有矿物质,通过加湿器会产生大量的 PM2.5(白色粉末),污染空气,还能引起呼吸道疾病,这是真的吗?我们在一款超声波加湿器中加入自来水,一测,PM2.5 果然爆表!

再试试同一款加湿器中加入超纯水,这是实验室专用的,几乎没什么杂质。一看,PM2.5 依然爆表!

其实 PM2.5 爆表是由于加湿器喷出的水雾,被仪器误识别为 PM2.5,跟自来水的钙镁离子关系不大,且单纯就这些水雾颗粒,对人体也是没什么危害的。另外,冷蒸发加湿器我们也试了下,PM2.5 没有爆表,这与两种加湿器的工作原理是有关系的。

但是为了避免产生水垢,及对加湿器造成损害,魏老爸还是建议: 超声波加湿器使用纯净水或蒸馏水,尤其是水质硬度高的地方。
五、使用体验

网 Y 智 Z、海 E 两款加湿器无智能控湿或湿度显示,无法了解到即时湿度,房间内湿度大了也不好。
在安静的房间里,超声波加湿器的机器噪音还能接受,但机器运行时有滴水或流水的声音。如晚上使用,对声音比较敏感的朋友,要注意下。
美 D 加湿器风扇声音有点大,嗡嗡~~嗡嗡~~
六、综合结果

私信发送:加湿器 查看具体品牌
注:该结果综合了各产品的加湿量、实际加湿效果、除菌效果、使用体验等,数据仅针对测试样品,不涉及该品牌及品牌下其它产品,数据仅供参考。
七、加湿器使用建议
1、 大多加湿器除菌效果不理想,要定期清理、换水,避免细菌滋生,影响家人的健康,特别是老人和小孩。
2、 加湿器水箱及底座可以用清水清理,也可以用软毛刷蘸着醋,擦拭清洗,记得要用清水冲洗干净。
千万不要将消毒剂加入到加湿器中
千万不要将消毒剂加入到加湿器中
千万不要将消毒剂加入到加湿器中
!!!!!
(好奇的可以去了解下“杀人加湿器”事件......)

▲ 图片来源于网络
3、超声波加湿器建议使用纯净水或蒸馏水,避免产生水垢,而冷蒸发加湿器可使用自来水,但滤网要及时清理、更换。
4、使用加湿器湿度也不能太高了,人体会感觉闷热潮湿,还会滋生细菌,容易发霉等,建议选有智能模式、控制湿度的加湿器。
5、孕妇在使用加湿器时不要加入香薰、精油等,以免引起不适。
我是魏老爸,一个用检测手段发现身边看不见的危害的杭州普通家长,欢迎关注我的头条号。
如果你想了解更多关于我的故事,可以点击下方【了解更多】,看完这个视频你会觉得相见恨晚!